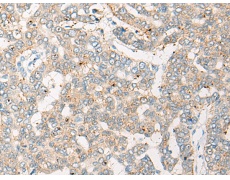
一抗

中文名稱: 兔抗CRAT多克隆抗體
|
Background: |
This gene encodes carnitine acetyltransferase (CRAT), which is a key enzyme in the metabolic pathway in mitochondria, peroxisomes and endoplasmic reticulum. CRAT catalyzes the reversible transfer of acyl groups from an acyl-CoA thioester to carnitine and regulates the ratio of acylCoA/CoA in the subcellular compartments. Two transcript variants encoding different isoforms have been found for this gene. |
|
Applications: |
ELISA, IHC |
|
Name of antibody: |
CRAT |
|
Immunogen: |
Fusion protein of human CRAT |
|
Full name: |
carnitine O-acetyltransferase |
|
Synonyms: |
CAT1 |
|
SwissProt: |
P43155 |
|
ELISA Recommended dilution: |
5000-10000 |
|
IHC positive control: |
Human esophagus cancer and Human liver cancer |
|
IHC Recommend dilution: |
20-100 |



 購物車
購物車 幫助
幫助
 021-54845833/15800441009
021-54845833/15800441009